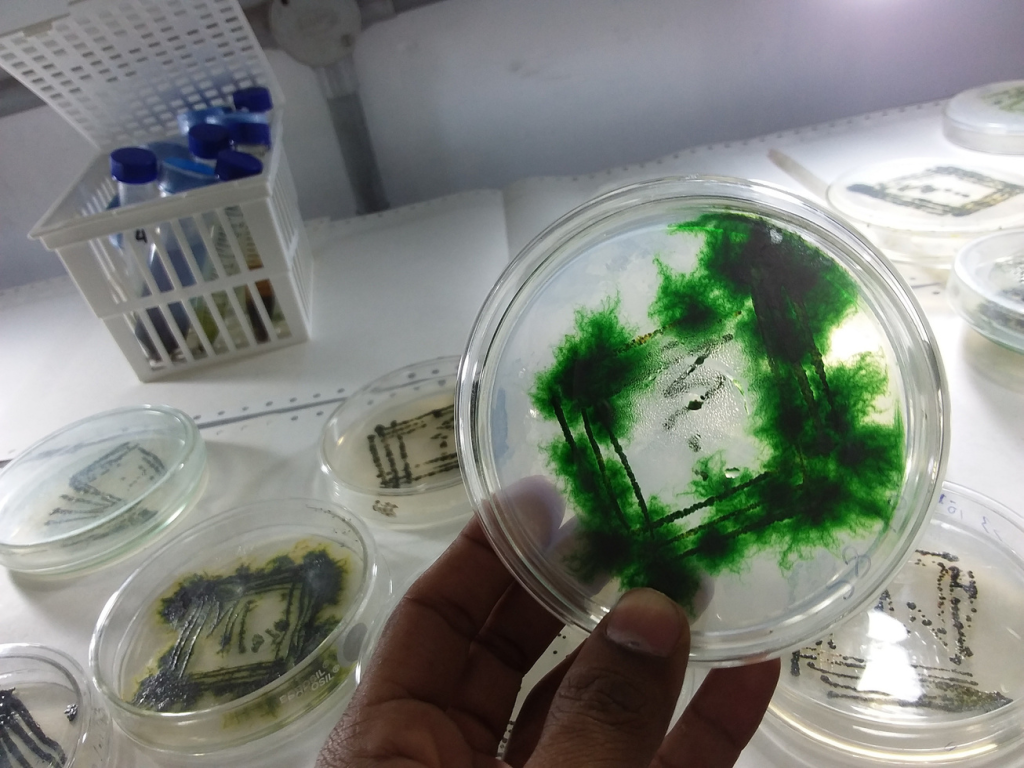

Spirulina, czyli biomasa sinic z rodzaju Arthrospira (głównie A. platensis i A. maxima), jest bogatym źródłem białka, witamin, minerałów oraz substancji bioaktywnych o udowodnionych właściwościach przeciwutleniających, przeciwzapalnych i immunomodulacyjnych. W ostatnich latach coraz częściej analizuje się jej potencjalny wpływ ochronny na narządy narażone na stres oksydacyjny i działanie toksyn — w tym szczególnie nerki, które pełnią kluczową rolę w detoksykacji i utrzymaniu homeostazy organizmu.
Mechanizmy ochronne spiruliny wobec nerek
1. Działanie przeciwutleniające
Jednym z głównych mechanizmów nefroprotekcyjnych spiruliny jest jej silna aktywność antyoksydacyjna. Zawarte w niej związki, takie jak fikocyjanina C, chlorofil, β-karoten, zeaksantyna oraz witaminy A, C i E, neutralizują wolne rodniki i reaktywne formy tlenu (ROS), które odpowiadają za uszkodzenia komórek kanalików nerkowych.
W badaniach na zwierzętach suplementacja spiruliną zwiększała aktywność enzymów antyoksydacyjnych, takich jak dysmutaza ponadtlenkowa (SOD), katalaza i peroksydaza glutationowa, co chroniło nerki przed degeneracją oksydacyjną.
2. Właściwości przeciwzapalne
Nerki są szczególnie narażone na przewlekłe mikrozapalenia towarzyszące chorobom metabolicznym, takim jak cukrzyca czy nadciśnienie. Obecna w spirulinie fikocyjanina wykazuje działanie przeciwzapalne poprzez hamowanie aktywności cyklooksygenazy (COX-2) oraz redukcję wytwarzania cytokin prozapalnych (IL-1β, TNF-α, IL-6). Dzięki temu może ograniczać postępujące uszkodzenie kłębuszków nerkowych i włóknienie miąższu nerek.
3. Wpływ na gospodarkę węglowodanową i lipidową
Spirulina poprawia parametry gospodarki glukozowej i lipidowej, co pośrednio wpływa korzystnie na stan nerek, zwłaszcza u osób z cukrzycą typu 2 i dyslipidemią. Obniżenie poziomu glukozy, cholesterolu LDL i triacylogliceroli zmniejsza stres metaboliczny oraz ilość produktów końcowych glikacji (AGE), które przyczyniają się do uszkodzeń naczyń nerkowych.
W badaniach klinicznych u pacjentów z cukrzycą suplementacja Spirulina maxima (2 g dziennie przez 2 miesiące) prowadziła do istotnej redukcji glikemii i hemoglobiny glikowanej.
4. Wpływ na ciśnienie tętnicze i perfuzję nerek
Nadciśnienie tętnicze jest jednym z głównych czynników rozwoju nefropatii. Spirulina może wspierać funkcjonowanie nerek poprzez obniżanie ciśnienia tętniczego — zarówno skurczowego, jak i rozkurczowego. Mechanizm ten związany jest z obecnością peptydu IQP (Ile-Gln-Pro), który działa jako naturalny inhibitor konwertazy angiotensyny (ACE), a także z poprawą syntezy tlenku azotu (NO) przez śródbłonek naczyniowy. Lepsze ukrwienie nerek sprzyja efektywnemu oczyszczaniu krwi i utrzymaniu prawidłowej filtracji kłębuszkowej (GFR).
5. Działanie detoksykacyjne
Spirulina jest znana z właściwości wiązania i eliminacji metali ciężkich, takich jak arsen, kadm, rtęć i ołów, które kumulują się w tkance nerkowej i mogą prowadzić do przewlekłej niewydolności nerek. Związki polisacharydowe obecne w ścianie komórkowej sinic (m.in. ramnoza, glukozamina) wiążą jony metali i ułatwiają ich wydalanie z organizmu, zmniejszając toksyczne obciążenie układu moczowego.
Badania nad nefroprotekcyjnym działaniem spiruliny
Eksperymenty na modelach zwierzęcych potwierdziły, że spirulina chroni nerki przed uszkodzeniami wywołanymi toksynami, stresem oksydacyjnym czy cukrzycą. W badaniach na szczurach suplementacja ekstraktem z Arthrospira platensis zapobiegała wzrostowi stężeń kreatyniny i mocznika w surowicy po ekspozycji na nefrotoksyczne związki (np. cisplatynę lub kadm). Dodatkowo obserwowano mniejsze zmiany histopatologiczne w tkance nerkowej oraz lepsze nawodnienie komórek kanalików [badania in vivo, m.in. Mohan et al., 2015].
Możliwe zastosowania kliniczne
Ze względu na swoje właściwości spirulina może znaleźć zastosowanie:
– w profilaktyce przewlekłej choroby nerek (CKD),
– – u osób z nadciśnieniem i cukrzycą typu 2,
– jako suplement wspierający funkcje filtracyjne u pacjentów po ekspozycji na toksyny środowiskowe,
– w terapii wspomagającej po chemioterapii lub długotrwałym leczeniu farmakologicznym obciążającym nerki.
Podsumowanie
Spirulina, dzięki zawartości licznych związków bioaktywnych — fikocyjaniny, chlorofilu, witamin, mikroelementów i nienasyconych kwasów tłuszczowych — wykazuje potencjalne działanie nefroprotekcyjne. Poprzez właściwości antyoksydacyjne, przeciwzapalne, detoksykacyjne oraz wpływ na regulację ciśnienia tętniczego i metabolizmu glukozy, może stanowić cenne uzupełnienie profilaktyki chorób nerek. Konieczne są jednak dalsze badania kliniczne, które pozwolą jednoznacznie określić skuteczność i optymalne dawki spiruliny w ochronie nerek u ludzi.
Badania naukowe:
SPIRULINA PLATENSIS PROTECTS AGAINST RENAL … – N. Avdagić i wsp., 2008: „Spirulina platensis protects against gentamicin-induced nephrotoxicity in rats”. Dostępny pełny tekst: https://www.ncbi.nlm.nih.gov/pmc/articles/PMC5677276/
Prospective protective effects of Arthrospira platensis against acetaminophen induced hepato‑renal toxicity in rats – A-
F. Salah & A. A. A. El-Sayed, 2023: badanie na szczurach dotyczące toksyczności paracetamolu i działania ochronnego spiruliny na wątrobę i nerki. PDF pełny tekst: https://www.scielo.cl/pdf/ijmorphol/v41n3/0717-9502-ijmorphol-41-03-975.pdf
Arthrospira maxima (Spirulina) and C‑phycocyanin prevent … – I. N. Memije-Lazaro i wsp., 2018: badanie na modelu choroby nerek („chronic kidney disease related causes”) u zwierząt przy podaniu Arthrospira maxima lub fikocyjaniny. Dostęp: https://www.sciencedirect.com/science/article/abs/10.1177/2397847318805070
Phytochemical evaluation, safety profile and hepato‑renal … – M. Bhadauria i wsp., 2025: „Phytochemical evaluation, safety profile and hepato-renal dysfunctions” – ocena potencjału ochronnego spiruliny wobec funkcji wątroby i nerek. https://www.sciencedirect.com/science/article/abs/pii/S2950199725001004
Application of Arthrospira platensis for Medicinal Purposes … – G. Gentscheva i wsp., 2023: Przeglądowy artykuł odnoszący się także do wpływu Arthrospira na funkcje narządowe, w tym nerek. Pełny tekst: https://www.mdpi.com/2075-1729/13/3/845
The Remedial Efficacy of Spirulina platensis versus Chromium‑Induced Nephrotoxicity in Male Sprague‑Dawley Rats (El-Shazly M O et al., 2015) https://pmc.ncbi.nlm.nih.gov/articles/PMC4450866/
Opis: W badaniu 36 samców szczurów Sprague-Dawley podzielono na grupy, w tym grupę kontrolną, grupę eksponowaną na dichromian sodu (toksyna do nerek) oraz grupy, które otrzymywały jednocześnie spirulinę (300 mg/kg m.c.) i dichromian. Wyniki: podanie toksyny powodowało wzrost poziomów mocznika i kreatyniny, uszkodzenia histologiczne nerek (nekróza kanalików, uszkodzenia kłębuszków). W grupie z suplementacją spiruliną zaobserwowano istotne zmniejszenie tych szkodliwych zmian — lepsze parametry nerkowe, mniejszy uszkodzony obszar w nerkach, poprawiona aktywność enzymów antyoksydacyjnych. Konkluzja: Spirulina wykazała działanie ochronne wobec toksycznej nerkowej ekspozycji u szczurów.
Spirulina platensis protects against gentamicin‑induced nephrotoxicity in rats (Data L.S. et al., 2008)
https://pubmed.ncbi.nlm.nih.gov/18690652/
Opis: W badaniu szczury poddano działaniu gentamycyny (antybiotyk nefrotoksyczny). Część grup otrzymywała dodatkowo spirulinę (1000 mg/kg) przez siedem dni. Znaleziono: spirulina zmniejszyła lipidową peroksydację w nerkach (MDA), zwiększyła aktywność glutationu, SOD i GPx, obniżyła poziom kreatyniny i mocznika, oraz ograniczyła histologiczne uszkodzenia nerek. Wniosek: Spirulina może działać jako ochrona przeciwko uszkodzeniom nerek wywołanym nefrotoksycznością.